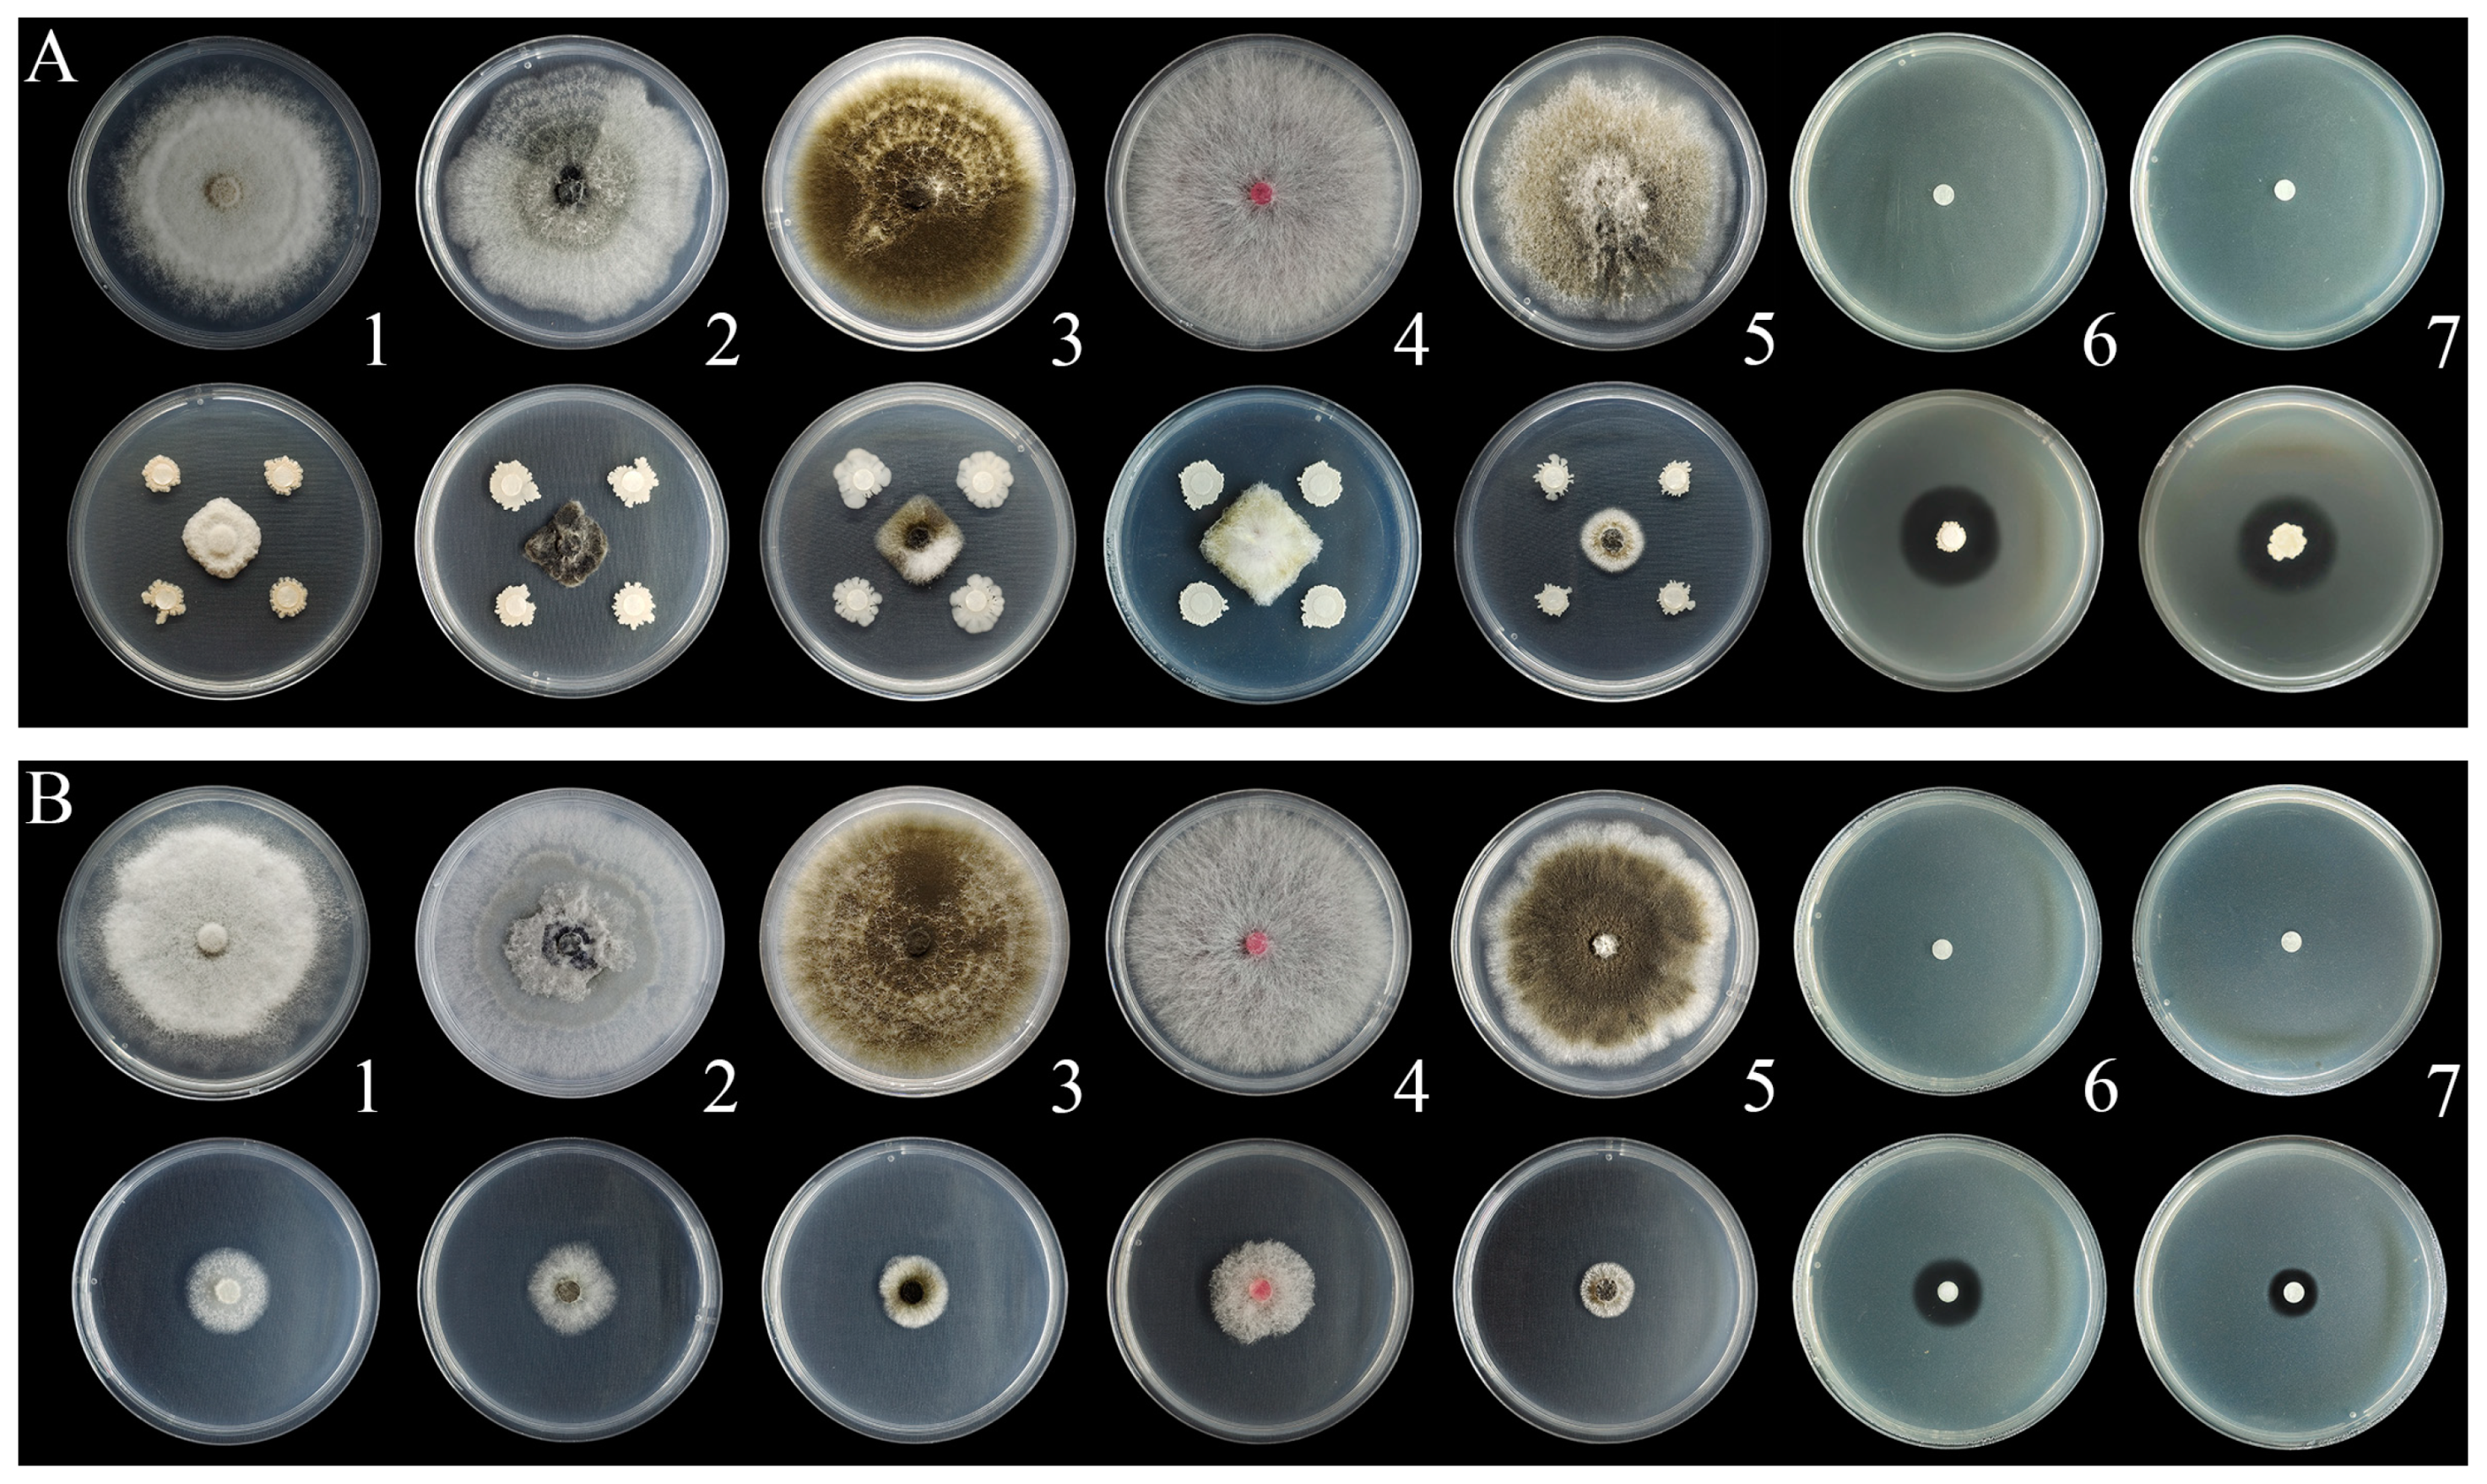
Ijms 24 11541 g002 Ijms 24 11541 g002

Assessment of the Biocontrol Potential of Bacillus velezensis WL–23 against Kiwifruit Canker Caused by Pseudomonas syringae pv. actinidiae
Abstract
1. Introduction
2. Results
2.1. Identification of the Bacterial Pathogen
2.2. Screening and Identification of Psa Antagonistic Strains In Vitro
2.3. Inhibitory Activity against Kiwifruit Pathogens
2.4. Effects of Aseptic Filtrate (AF) on Growth Curve of Psa
2.5. Effects of AF on Cell Permeability
2.6. Effects of AF on Cell Morphology and the Internal Structure of Psa
2.7. Effects of WL–23 on Kiwifruit
2.7.1. Induced Kiwifruit Resistance
2.7.2. Promotion of Plant Growth
2.8. In Vivo Control of Psa by AF
3. Discussion
4. Materials and Methods
4.1. Isolation and Confirmation of the Bacterial Pathogen
4.2. Isolation and Screening of Antagonistic Bacteria In Vitro
4.3. Identification of Antagonistic Bacteria
4.4. Preparation of WL–23 Bacterial Suspension and Its Aseptic Filtrate (AF)
4.5. Inhibition Spectrum of the Antagonistic Bacterium and Its AF
4.6. Effects of AF on Psa Growth
4.7. Cell Permeability
4.8. Effects of AF on Cell Morphology and Internal Structure of Psa
4.9. Effects of WL–23 on Kiwifruit
4.9.1. Induced Kiwifruit Resistance
4.9.2. Promotion of Plant Growth
4.10. In Vivo Prevention Assay
4.11. Statistical Analysis
Supplementary Materials
Author Contributions
Funding
Institutional Review Board Statement
Informed Consent Statement
Data Availability Statement
Acknowledgments
Conflicts of Interest
References
- Vanneste, J.L. The scientific, economic, and social impacts of the New Zealand outbreak of bacterial canker of kiwifruit (Pseudomonas syringae pv. actinidiae). Annu. Rev. Phytopathol. 2017, 55, 377–399. [Google Scholar] [CrossRef] [PubMed]
- Donati, I.; Cellini, A.; Sangiorgiao, D.; Vanneste, J.L.; Scortichini, M.; Balestra, G.M.; Spinelli, F. Pseudomonas syringae pv. actinidiae: Ecology, infection dynamics and disease epidemiology. Microb. Ecol. 2020, 80, 81–102. [Google Scholar] [CrossRef] [PubMed]
- Donati, I.; Mauri, S.; Buriani, G.; Cellini, A.; Spinelli, F. Role of Metcalfa pruinosa as a vector for Pseudomonas syringae pv. actinidiae. Plant Pathol. J. 2017, 33, 554–560. [Google Scholar] [CrossRef]
- Donati, I.; Cellini, A.; Buriani, G.; Mauri, S.; Kay, C.; Tacconi, G.; Spinelli, F. Pathways of flower infection and pollen–mediated dispersion of Pseudomonas syringae pv. actinidiae, the causal agent of kiwifruit bacterial canker. Hort. Res. 2018, 5, 56. [Google Scholar] [CrossRef] [PubMed]
- McCann, H.C.; Rikkerink, E.H.; Bertels, F.; Fiers, M.; Lu, A.; Rees-George, J.; Andersen, M.T.; Gleave, A.P.; Haubold, B.; Whohlers, M.W.; et al. Genomic analysis of the kiwifruit pathogen Pseudomonas syringae pv. actinidiae provides insight into the origins of an emergent plant disease. PLoS Pathog. 2013, 9, e1003503. [Google Scholar] [CrossRef]
- Scortichini, M.; Marcelletti, S.; Ferrante, P.; Petriccione, M.; Firrao, G. Pseudomonas syringae pv. actinidiae: A re–emerging, multi–faceted, pandemic pathogen. Mol. Plant Pathol. 2012, 13, 631–640. [Google Scholar] [CrossRef]
- Vanneste, J.L. Pseudomonas syringae pv. actinidiae (Psa): A threat to the New Zealand and global kiwifruit industry. N. Zeal. J. Crop Hort. 2012, 40, 265–267. [Google Scholar] [CrossRef]
- Colombi, E.; Straub, C.; Künzel, S.; Templeton, M.D.; McCann, H.C.; Rainey, P.B. Evolution of copper resistance in the kiwifruit pathogen Pseudomonas syringae pv. actinidiae through acquisition of integrative conjugative elements and plasmids. Environ. Microbiol. 2017, 19, 819–832. [Google Scholar] [CrossRef]
- Daranas, N.; Roselló, G.; Cabrefiga, J.; Donati, I.; Francés, J.; Badosa, E.; Spinelli, F.; Montesinos, E.; Bonaterra, A. Biological control of bacterial plant diseases with Lactobacillus plantarum strains selected for their broad–spectrum activity. Ann. Appl. Biol. 2019, 174, 92–105. [Google Scholar] [CrossRef]
- Flores, O.; Retamales, J.; Núñez, M.; León, M.; Salinas, P.; Besoain, X.; Yañez, C.; Bastías, R. Characterization of Bacteriophages against Pseudomonas Syringae pv. actinidiae with potential use as natural antimicrobials in kiwifruit plants. Microorganisms 2020, 8, 974. [Google Scholar] [CrossRef]
- Pang, L.; Xia, B.; Liu, X.-B.; Yi, Y.-J.; Jiang, L.-W.; Chen, C.; Li, P.; Zhang, M.; Deng, X.-B.; Wang, R.-C. Improvement of antifungal activity of a culture filtrate of endophytic Bacillus amyloliquefaciens isolated from kiwifruit and its effect on postharvest quality of kiwifruit. J. Food Biochem. 2021, 45, e13551. [Google Scholar] [CrossRef] [PubMed]
- Abriouel, H.; Franz, C.M.; Ben, O.N.; Gálvez, A. Diversity and applications of Bacillus bacteriocins. FEMS Microbiol. Rev. 2011, 35, 201–232. [Google Scholar] [CrossRef] [PubMed]
- Zhao, P.-C.; Xue, Y.; Gao, W.-N.; Li, J.-H.; Zu, X.-Y.; Fu, D.-L.; Bai, X.-F.; Zuo, Y.-J.; Hu, Z.-G.; Zhang, F.-S. Bacillaceae–derived peptide antibiotics since 2000. Peptides 2018, 101, 10–16. [Google Scholar] [CrossRef] [PubMed]
- Zhao, X.; Kuipers, O.P. Identification and classification of known and putative antimicrobial compounds produced by a wide variety of Bacillales species. BMC Genom. 2016, 17, 882. [Google Scholar] [CrossRef]
- Pieterse, C.M.; Zamioudis, C.; Berendsen, R.L.; Weller, D.M.; Van Wees, S.C.; Bakker, P.A. Induced systemic resistance by beneficial microbes. Annu. Rev. Phytopathol. 2014, 52, 347–375. [Google Scholar] [CrossRef]
- Vejan, P.; Abdullah, R.; Khadiran, T.; Ismail, S.; Nasrulhaq Boyce, A. Role of plant growth promoting rhizobacteria in agricultural sustainability—A review. Molecules 2016, 21, 573. [Google Scholar] [CrossRef]
- Tsotetsi, T.; Nephali, L.; Malebe, M.; Tugizimana, F. Bacillus for plant growth promotion and stress resilience: What have we learned? Plants 2022, 11, 2482. [Google Scholar] [CrossRef]
- Chen, T.; Nomura, K.; Wang, X.-L.; Sohrabi, R.; Xu, J.; Yao, L.-Y.; Paasch, B.C.; Ma, L.; Kremre, J.; Cheng, Y.-T. A plant genetic network for preventing dysbiosis in the phyllosphere. Nature 2020, 580, 653–657. [Google Scholar] [CrossRef]
- Vorholt, J.A. Microbial life in the phyllosphere. Nat. Rev. Microbiol. 2021, 10, 828–840. [Google Scholar] [CrossRef]
- Getzke, F.; Thiergart, T.; Hacquard, S. Contribution of bacterial–fungal balance to plant and animal health. Curr. Opin. Microbiol. 2019, 49, 66–72. [Google Scholar] [CrossRef]
- Lopes, R.; Tsui, S.; Gonçalves, P.J.; de Queiroz, M.V. A look into a multifunctional toolbox: Endophytic Bacillus species provide broad and underexploited benefits for plants. World J. Microb. Biot. 2018, 34, 94. [Google Scholar] [CrossRef]
- Mateus, J.R.; Dal’Rio, I.; Jurelevicius, D.; da Mota, F.F.; Marques, J.M.; Ramos, R.T.; da Costa da Silva, A.L.; Gagliardi, P.R.; Seldin, L. Bacillus velezensis T149−19 and Bacillus safensis T052–76 as potential biocontrol agents against foot rot disease in sweet potato. Agriculture 2021, 11, 1046. [Google Scholar] [CrossRef]
- Riaz, R.; Khan, A.; Khan, W.J.; Jabeen, Z.; Yasmin, H.; Naz, R.; Nosheen, A.; Hassan, M.N. Vegetable associated Bacillus spp. suppress the pea (Pisum sativum L.) root rot caused by Fusarium solani. Biol. Control 2021, 158, 104610. [Google Scholar] [CrossRef]
- Yánez-Mendizábal, V.; Falconí, C.E. Efficacy of Bacillus spp. to biocontrol of anthracnose and enhance plant growth on Andean lupin seeds by lipopeptide production. Biol. Control 2018, 122, 67–75. [Google Scholar] [CrossRef]
- Chen, C.Z.; Cooper, S.L. Interactions between dendrimer biocides and bacterial membranes. Biomaterials 2002, 23, 3359–3368. [Google Scholar] [CrossRef] [PubMed]
- Xing, K.; Chen, X.-G.; Kong, M.; Liu, C.-S.; Cha, D.-S.; Park, H.-J. Effect of oleoyl–chitosan nanoparticles as a novel antibacterial dispersion system on viability, membrane permeability and cell morphology of Escherichia coli and Staphylococcus aureus. Carbohyd. Polym. 2009, 76, 17–22. [Google Scholar] [CrossRef]
- Cui, H.-Y.; Zhang, C.-H.; Li, C.-Z.; Lin, L. Antimicrobial mechanism of clove oil on Listeria monocytogenes. Food Control 2018, 94, 140–146. [Google Scholar] [CrossRef]
- Cao, B.-H.; Li, H.; Tian, S.-P.; Qin, G.-Z. Boron improves the biocontrol activity of Cryptococcus laurentii against Penicillium expansum in jujube fruit. Postharvest Biol. Tec. 2012, 68, 16–21. [Google Scholar] [CrossRef]
- Xue, Y.-B.; Yang, M.-G.; Li, S.-H.; Li, Z.-J.; Liu, H.-H.; Guo, Q.-B.; Wang, C.-L. The antibiotic activity and mechanisms of active metabolites (Streptomyces alboflavus TD–1) against Ralstonia solanacearum. Biotechnol. Lett. 2019, 41, 1213–1222. [Google Scholar] [CrossRef] [PubMed]
- Kim, B.; Park, A.R.; Song, C.W.; Song, H.S.; Kim, J.-C. Biological control efficacy and action mechanism of Klebsiella pneumoniae JCK-2201 producing meso-2,3-butanediol against tomato bacterial wilt. Front. Microbiol. 2022, 13, 914589. [Google Scholar] [CrossRef]
- Ma, T.; Yang, C.-D.; Cai, F.-F.; Cui, L.-X.; Wang, Y.-D. Optimizing fermentation of Bacillus amyloliquefaciens 3–5 and determining disease suppression and growth in cucumber (Cucumis sativus). Biol. Control 2022, 176, 105070. [Google Scholar] [CrossRef]
- Reglinski, T.; Vanneste, J.L.; Wuems, K.; Gould, E.; Spinelli, F.; Rikkerink, E. Using fundamental knowledge of induced resistance to develop control strategies for bacterial canker of kiwifruit caused by Pseudomonas syringae pv. actinidiae. Front. Plant Sci. 2013, 4, 24. [Google Scholar] [CrossRef]
- Reglinski, T.; Wurms, K.; Vanneste, J.; Ah Chee, A.; Yu, J.; Oldham, J.; Cornish, D.; Cooney, J.; Jensen, D.; Trower, T.; et al. Transient changes in defence gene expression and phytohormone content induced by acibenzolar-s-methyl in glasshouse and orchard grown kiwifruit. Front. Agron. 2022, 3, 831172. [Google Scholar] [CrossRef]
- de Jong, H.; Reglinski, T.; Elmer, P.A.G.; Wurms, K.; Vanneste, J.L.; Guo, L.F.; Alavi, M. Integrated Use of Aureobasidium pullulans strain CG163 and acibenzolar-s-methyl for management of bacterial canker in kiwifruit. Plants 2019, 8, 287. [Google Scholar] [CrossRef] [PubMed]
- Kloepper, J.W.; Tuzun, S.; Kuc, J.A. Proposed definitions related to induced disease resistance. Biocontrol. Sci. Technol. 1992, 2, 349–351. [Google Scholar] [CrossRef]
- Conrath, U.; Beckers, G.J.M.; Flors, V.; García-Agustín, P.; Jakab, G.; Mauch, F.; Newman, M.-A.; Pieterse, C.M.J.; Poinssot, B.; Pozo, M.J.; et al. Priming: Getting ready for battle. Mol. Plant Microbe Interact. 2006, 19, 1062–1071. [Google Scholar] [CrossRef]
- Wang, M.; Xue, J.; Ma, J.; Feng, X.; Ying, H.; Xu, H. Streptomyces lydicus M01 regulates soil microbial community and alleviates foliar disease caused by Alternaria alternataon cucumbers. Front. Microbiol. 2020, 11, 942. [Google Scholar] [CrossRef] [PubMed]
- Yu, Y.; Gui, Y.; Li, Z.; Jiang, C.; Guo, J.; Niu, D. Induced systemic resistance for improving plant immunity by beneficial microbes. Plants 2022, 11, 386. [Google Scholar] [CrossRef]
- Liu, J.; Wisniewski, M.; Droby, S.; Vero, S.; Tian, S.P.; Hershkovitz, V. Glycine betaine improves oxidative stress tolerance and biocontrol efficacy of the antagonistic yeast Cystofilobasidium infirmominiatum. Int. J. Food Microbiol. 2011, 146, 76–83. [Google Scholar] [CrossRef]
- Goupy, P.; Amiot, M.J.; Richard-Forget, F.; Duprat, F.; Aubert, S.; Nicolas, J. Enzymatic browning of model solutions and apple phenolic extracts by apple polyphenoloxidase. J. Food Sci. 1995, 60, 497–501. [Google Scholar] [CrossRef]
- Zhang, H.-Y.; Chen, L.-L.; Sun, Y.-W.; Zhao, L.-N.; Zheng, X.-F.; Yang, Q.-Y.; Zhang, X.-Y. Investigating proteome and transcriptome defense response of apples induced by Yarrowia lipolytica. Mol. Plant–Microbe Interact. 2017, 30, 301–311. [Google Scholar] [CrossRef] [PubMed]
- Ben Khedher, S.; Mejdoub-Trabelsi, B.; Tounsi, S. Biological potential of Bacillus subtilis V26 for the control of Fusarium wilt and tuber dry rot on potato caused by Fusarium species and the promotion of plant growth. Biol. Control 2021, 152, 104444. [Google Scholar] [CrossRef]
- Bhusal, B.; Mmbaga, M.T. Biological control of Phytophthora blight and growth promotion in sweet pepper by Bacillus species. Biol. Control 2020, 150, 104373. [Google Scholar] [CrossRef]
- Gu, G.-F.; Yang, S.; Yin, X.-H.; Long, Y.-H.; Ma, Y.; Li, R.-Y.; Wang, G.-L. Sulfur induces resistance against canker caused by Pseudomonas syringae pv. actinidae via phenolic components increase and morphological structure modification in the kiwifruit stems. Int. J. Mol. Sci. 2021, 22, 12185. [Google Scholar] [CrossRef]
- Kim, M.J.; Chae, D.H.; Cho, G.; Kim, D.R.; Kwak, Y.S. Characterization of Antibacterial Strains against Kiwifruit Bacterial Canker Pathogen. Plant Pathol. J. 2019, 35, 473–485. [Google Scholar] [CrossRef] [PubMed]
- Wang, F.-M.; Mo, Q.-H.; Ye, K.-Y.; Gong, H.-J.; Qi, B.-B.; Liu, P.-P.; Jiang, Q.-S. Evaluation of the wild Actinidia germplasm for resistance to Pseudomonas syringae pv. actinidiae. Plant Pathol. 2020, 69, 979–989. [Google Scholar] [CrossRef]
- Xu, W.; Zhang, L.-Y.; Goodwin, P.-H.; Xia, M.-C.; Zhang, J.; Wang, Q.; Liang, J.; Sun, R.-H.; Wu, C.; Yang, L.-R. Isolation, identification, and complete genome assembly of an endophytic Bacillus velezensis YB–130, potential biocontrol agent against Fusarium graminearum. Front. Microbiol. 2020, 11, 598285. [Google Scholar] [CrossRef]
- Balestra, G.M.; Taratufolo, M.C.; Vinatzer, B.A.; Mazzaglia, A. A multiplex PCR assay for detection of Pseudomonas syringae pv. actinidiae and differentiation of populations with different geographic origin. Plant Dis. 2013, 97, 472–478. [Google Scholar] [CrossRef]
- Koh, H.S.; Kim, G.H.; Lee, Y.S.; Koh, Y.J.; Jung, J.S. Molecular characteristics of Pseudomonas syringae pv. actinidiae strains isolated in Korea and a multiplex PCR assay for haplotype differentiation. Plant Pathol. J. 2014, 30, 96–101. [Google Scholar] [CrossRef]
- Scortichini, M. Aspects still to solve for the management of kiwifruit bacterial canker caused by Pseudomonas syringae pv. actinidiae biovar 3. Eur. J. Hortic. Sci. 2018, 1218, 219–226. [Google Scholar] [CrossRef]
- Wang, B.-C.; Lei, X.; Chen, J.; Li, W.-Z.; Long, Y.-H.; Wang, W.-Z. Antifungal activities of Bacillus mojavensis BQ–33 towards the kiwifruit black spot disease caused by the fungal pathogen Didymella glomerata. Microorganisms 2022, 10, 2085. [Google Scholar] [CrossRef]
- Yang, F.-Z.; Zhang, R.-Y.; Wu, X.-Y.; Xu, T.-J.; Ahmad, S.; Zhang, X.-X.; Zhang, J.-R.; Liu, Y. An endophytic strain of the genus Bacillus isolated from the seeds of maize (Zea mays L.) has antagonistic activity against maize pathogenic strains. Microb. Pathog. 2020, 142, 104074. [Google Scholar] [CrossRef]
- Li, W.-Z.; Long, Y.-H.; Mo, F.-X.; Shu, R.; Yin, X.-H.; Wu, X.-M. Antifungal activity and biocontrol mechanism of Fusicolla violacea J–1 against soft rot in kiwifruit caused by Alternaria alternata. J. Fungi 2021, 7, 937. [Google Scholar] [CrossRef] [PubMed]
- Xie, Z.-Y.; Li, M.-M.; Wang, D.-K.; Wang, F.-L.; Shen, H.; Sun, G.-J.; Feng, C.; Wang, X.-Q.; Chen, D.-X.; Sun, X.-C. Biocontrol efficacy of Bacillus siamensis LZ88 against brown spot disease of tobacco caused by Alternaria alternata. Biol. Control 2021, 154, 104508. [Google Scholar] [CrossRef]
- Chen, C.; Cao, Z.; Li, J.; Tao, C.; Feng, Y.-N.; Han, Y.-L. A novel endophytic strain of Lactobacillus plantarum CM–3 with antagonistic activity against Botrytis cinerea on strawberry fruit. Biol. Control 2020, 148, 104306. [Google Scholar] [CrossRef]
- Huang, C.-X.; Xu, G.-Q.; Wang, L.-H.; Zhang, P.; Zhao, P.-W.; Zhong, Y. Antagonistic properties and screening of Bacillus velezensis Nhw–B72 against wood fungal decay. Forests 2021, 12, 785. [Google Scholar] [CrossRef]
- Liu, H.; Pang, L.; Lu, X.; Wang, R.-C.; Zhou, Q. First report of Phomopsis longicolla associated with postharvest fruit rot of kiwifruit in China. Plant Dis. 2019, 104, 579–580. [Google Scholar] [CrossRef]
- Wang, L.; Hou, H.; Zhou, Z.-Q.; Tu, H.-T.; Yuan, H.-B. Identification and detection of Botryosphaeria dothidea from kiwifruit (Actinidia chinensis) in China. Plants 2021, 10, 401. [Google Scholar] [CrossRef] [PubMed]
- Li, L.; Pan, H.; Liu, W.; Chen, M.-Y.; Zhong, C.-H. First report of Alternaria alternata causing postharvest rot of kiwifruit in China. Plant Dis. 2017, 101, 1046–1047. [Google Scholar] [CrossRef]
- Chen, J.; Ran, F.; Shi, J.-Q.; Chen, T.-T.; Zhao, Z.-B.; Zhang, Z.-Z.; He, L.-L.; Li, W.-Z.; Wang, B.-C.; Chen, X.-T. Identification of the causal agent of brown leaf spot on kiwifruit and its sensitivity to different active ingredients of biological fungicides. Pathogens 2022, 11, 673. [Google Scholar] [CrossRef]
- Pan, H.; Chen, M.-Y.; Deng, L.; Wang, Z.-P.; Li, L.; Zhong, C.-H. First report of Didymella glomerata causing black spot disease of kiwifruit in China. Plant Dis. 2018, 102, 2654. [Google Scholar] [CrossRef]
- Chapman, J.R.; Taylor, R.K.; Weir, B.S.; Romberg, M.K.; Vanneste, J.L.; Luck, J.; Alexander, B.J.R. Phylogenetic relationships among global populations of Pseudomonas syringae pv. actinidiae. Phytopathology 2012, 102, 1034–1044. [Google Scholar] [CrossRef] [PubMed]
- He, L.-N.; Shi, J.-Q.; Zhao, Z.-B.; Ran, F.; Mo, F.-X.; Long, Y.-H.; Yin, X.-H.; Li, W.-Z.; Chen, T.-T.; Chen, J. First report of crown gall of kiwifruit (Actinidia deliciosa) caused by Agrobacterium fabacearum in China and the establishment of loop–mediated isothermal amplification technique. Int. J. Mol. Sci. 2021, 23, 207. [Google Scholar] [CrossRef]
- Zheng, T.-W.; Liu, L.; Nie, Q.-W.; Hsiang, T.; Sun, Z.-X.; Zhou, Y. Isolation, identification and biocontrol mechanisms of endophytic bacterium D61–A from Fraxinus hupehensis against Rhizoctonia solani. Biol. Control 2021, 158, 104621. [Google Scholar] [CrossRef]
- Wu, L.-M.; Wu, H.-J.; Chen, L.-N.; Yu, X.-F.; Borriss, R.; Gao, X.-W. Difficidin and bacilysin from Bacillus amyloliquefaciens FZB42 have antibacterial activity against Xanthomonas oryzae rice pathogens. Sci. Rep. 2015, 5, 12975. [Google Scholar] [CrossRef]
- Cui, W.-Y.; He, P.-J.; Munir, S.; He, P.-O.; Li, X.-Y.; Li, Y.-M.; Wu, J.-J.; Wu, Y.-X.; Yang, L.-J.; He, P.-F. Efficacy of plant growth promoting bacteria Bacillus amyloliquefaciens B9601–Y2 for biocontrol of southern corn leaf blight. Biol. Control 2019, 139, 104080. [Google Scholar] [CrossRef]
- Shu, Q.; Niu, Y.-W.; Zhao, W.-J.; Chen, Q.-H. Antibacterial activity and mannosylerythritol lipids against vegetative cells and spores of Bacillus cereus. Food Control 2019, 106, 106711. [Google Scholar] [CrossRef]
- Hu, W.; Li, C.-Z.; Dai, J.-M.; Cui, H.-Y.; Lin, L. Antibacterial activity and mechanism of Litsea cubeba essential oil against methicillin–resistant Staphylococcus aureus (MRSA). Ind. Crops Prod. 2019, 130, 34–41. [Google Scholar] [CrossRef]
- Diao, W.-R.; Hu, Q.-P.; Zhang, H.; Xu, J.-G. Chemical composition, antibacterial activity and mechanism of action of essential oil from seeds of fennel (Foeniculum vulgare Mill.). Food Control 2014, 35, 109–116. [Google Scholar] [CrossRef]
- Cui, H.-Y.; Bai, M.; Lin, L. Plasma–treated poly (ethylene oxide) nanofibers containing tea tree oil/beta–cyclodextrin inclusion complex for antibacterial packaging. Carbohydr. Polym. 2018, 179, 360–369. [Google Scholar] [CrossRef]
- Fei, P.; Xu, Y.-F.; Zhao, S.-J.; Gong, S.-Y.; Guo, L. Olive oil polyphenol extract inhibits vegetative cells of Bacillus cereus isolated from raw milk. J. Dairy Sci. 2019, 102, 3894–3902. [Google Scholar] [CrossRef] [PubMed]
- Wang, Y.F.-F.; Tang, F.; Xia, J.-D.; Yu, T.; Wang, J.; Azhati, R.; Zheng, X.-D. A combination of marine yeast and food additive enhances preventive effects on postharvest decay of jujubes (Zizyphus jujuba). Food Chem. 2011, 125, 835–840. [Google Scholar] [CrossRef]
- Mahunu, G.K.; Zhang, H.-Y.; Yang, Q.-Y.; Zhang, X.-Y.; Li, D.-D.; Zhou, Y.-X. Improving the biocontrol efficacy of Pichia caribbica with phytic acid against postharvest blue mold and natural decay in apples. Biol. Control 2016, 92, 172–180. [Google Scholar] [CrossRef]
- Mohammadi, M.; Kazemi, H. Changes in peroxidase and polyphenol oxidase activities in susceptible and resistant wheat heads inoculated with Fusarium graminearum and induced resistance. Plant Sci. 2002, 162, 491–498. [Google Scholar] [CrossRef]
- Yu, T.; Zhang, H.-Y.; Li, X.-L.; Zheng, X.-D. Biocontrol of Botrytis cinerea in apple fruit by Cryptococcus laurentii and indole–3–acetic acid. Biol. Control 2008, 46, 171–177. [Google Scholar] [CrossRef]
- Pinheiro, L.A.M.; Pereira, C.; Barreal, M.E.; Gallego, P.P.; Balcão, V.M.; Almeida, A. Use of phage ϕ6 to inactivate Pseudomonas syringae pv. actinidiae in kiwifruit plants: In vitro and ex vivo experiments. Appl. Microbiol. Biotechnol. 2020, 104, 1319–1330. [Google Scholar] [CrossRef]
- Nita, M.; Ellis, M.A.; Wilson, L.L.; Madden, L.V. Effects of application of fungicide during the dormant period on Phomopsis cane and leaf spot of grape disease intensity and inoculum production. Plant Dis. 2006, 90, 1195–1200. [Google Scholar] [CrossRef]
- Shi, J.-Y.; Liu, A.-Y.; Li, X.-P.; Feng, S.-J.; Chen, W.-X. Identification of endophytic bacterial strain MGP1 selected from papaya and its biocontrol effects on pathogens infecting harvested papaya fruit. J. Sci. Food Agric. 2010, 90, 227–232. [Google Scholar] [CrossRef]

| Fungal Pathogens | Inhibition Ratio by WL–23 (%) | Inhibition Ratio by AF (%) |
|---|---|---|
| Phomopsis longicolla | 74.04 ± 0.55 bc | 78.87 ± 0.52 b |
| Botryosphaeria dothidea | 71.83 ± 0.76 c | 73.33 ± 0.56 d |
| Alternaria alternata | 75.02 ± 0.41 b | 76.18 ± 0.72 c |
| Fusarium graminearum | 66.62 ± 1.10 d | 69.40 ± 1.02 e |
| Didymella glomerata | 79.76 ± 0.61 a | 81.96 ± 0.32 a |
| Bacterial Pathogens | Inhibition Zone Diameter by WL–23 (mm) | Inhibition Zone Diameter by AF (mm) |
|---|---|---|
| Pseudomonas syringae pv. actinidiae | 27.6 ± 0.44 a | 18.58 ± 0.43 a |
| Agrobacterium fabacearum | 22.54 ± 0.48 b | 16.02 ± 0.30 b |
| Treatment | Disease Index | Control Effect (%) |
|---|---|---|
| Control | 80.00 ± 3.85 a | – |
| 25% AF | 51.11 ± 4.44 b | 36.11 ± 5.55 c |
| 50% AF | 37.78 ± 5.88 c | 52.77 ± 7.35 b |
| Undiluted | 26.67 ± 3.85 cd | 66.67 ± 4.81 ab |
| WL–23 | 22.22 ± 2.22 d | 72.22 ± 2.78 a |
| Pathogens | Disease Type |
|---|---|
| Phomopsis longicolla | Kiwifruit postharvest rot [57] |
| Botryosphaeria dothidea | Kiwifruit soft rot [58] |
| Alternaria alternata | Kiwifruit postharvest rot [59] |
| Fusarium graminearum | Kiwifruit brown leaf spot [60] |
| Didymella glomerata | Kiwifruit black spot [61] |
| Pseudomonas syringae pv. actinidiae | Kiwifruit canker [62] |
| Agrobacterium fabacearum | Kiwifruit crown gall [63] |
Disclaimer/Publisher’s Note: The statements, opinions and data contained in all publications are solely those of the individual author(s) and contributor(s) and not of MDPI and/or the editor(s). MDPI and/or the editor(s) disclaim responsibility for any injury to people or property resulting from any ideas, methods, instructions or products referred to in the content. |
© 2023 by the authors. Licensee MDPI, Basel, Switzerland. This article is an open access article distributed under the terms and conditions of the Creative Commons Attribution (CC BY) license (https://creativecommons.org/licenses/by/4.0/).
Share and Cite
Wang, B.; Guo, Y.; Chen, X.; Ma, J.; Lei, X.; Wang, W.; Long, Y. Assessment of the Biocontrol Potential of Bacillus velezensis WL–23 against Kiwifruit Canker Caused by Pseudomonas syringae pv. actinidiae. Int. J. Mol. Sci. 2023, 24, 11541. https://doi.org/10.3390/ijms241411541
Wang B, Guo Y, Chen X, Ma J, Lei X, Wang W, Long Y. Assessment of the Biocontrol Potential of Bacillus velezensis WL–23 against Kiwifruit Canker Caused by Pseudomonas syringae pv. actinidiae. International Journal of Molecular Sciences. 2023; 24(14):11541. https://doi.org/10.3390/ijms241411541
Chicago/Turabian StyleWang, Bingce, Yushan Guo, Xuetang Chen, Jiling Ma, Xia Lei, Weizhen Wang, and Youhua Long. 2023. "Assessment of the Biocontrol Potential of Bacillus velezensis WL–23 against Kiwifruit Canker Caused by Pseudomonas syringae pv. actinidiae" International Journal of Molecular Sciences 24, no. 14: 11541. https://doi.org/10.3390/ijms241411541
APA StyleWang, B., Guo, Y., Chen, X., Ma, J., Lei, X., Wang, W., & Long, Y. (2023). Assessment of the Biocontrol Potential of Bacillus velezensis WL–23 against Kiwifruit Canker Caused by Pseudomonas syringae pv. actinidiae. International Journal of Molecular Sciences, 24(14), 11541. https://doi.org/10.3390/ijms241411541
